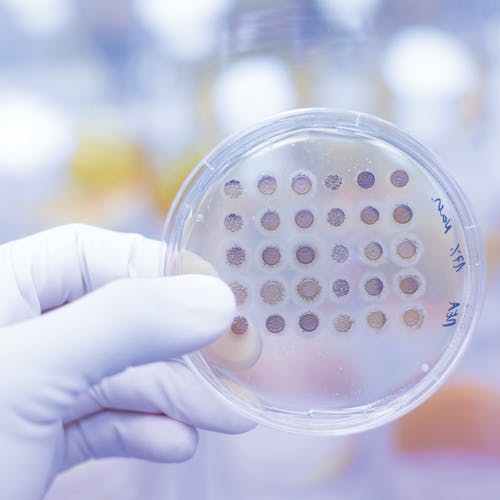

Israeli Start-up Developing Home Diagnostic Kit

Imagine you haven’t been feeling well and sense something is wrong, but it’s difficult to make it to the doctor’s office to be tested and diagnosed. Perhaps you live in a remote location or don’t want to wait several weeks for an appointment. Jerusalem-based start-up Diagnoz.me is seeking to solve this problem and revolutionize modern healthcare by developing a home diagnostic kit, making it possible for patients to test their own samples using a disposable chip paired with a smartphone and have the results analyzed and instantly sent to their physicians to write a prescription or begin treatment.
“Our innovation is that we enable the smartphone to see bacteria,” cofounder Ariel Livne told Israel21c. “Once you see bacteria, you can perform medical diagnostics. Our technology transforms a low-cost disposable together with a regular smartphone into a high-end medical diagnostics microscope.”
Livne, a biologist who cofounded Diagnoz.me in 2017 with businessman Tamir Epstein, said their image-analysis software “can detect bacteria as accurately as a high-end lab microscope that costs over [US] $100,000.”
The end-goal is to create a disposable chip on which users could place different types of body fluid—urine, saliva or a tear drop—“in a convenient way so it’s not disgusting or unhygienic. The camera takes and analyzes the pictures and sends you and your physician automatic results,” Livne told Israel21c.
The disposable devices, which would be sold for under US $20 at pharmacies, are still in the research and development phase. Diagnoz.me received start-up funding from the Israel Innovation Authority, but the company is seeking further funding. Israel21c reported that Livne estimated the product will take two to three years to reach the market.

Discover Your Purpose and God’s Heart For You
In today's divided, turbulent world, it's essential for the Church to rediscover God's heart. Our free e-book, authored by a seasoned expert with three decades of experience in Israel, delves deep into the teachings of Jesus (Yeshua) to reveal God’s principles of love and purpose. Learn how embracing these truths can bring significance and impact to your life, even amidst chaos. Subscribe now to receive your free copy and embark on a journey of transformation.




